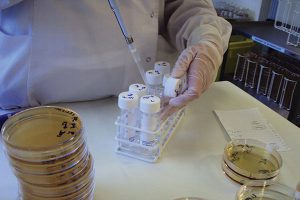

-
Team Homeopathy 360
Posts

Indore: AYUSH ministry invites Dr Dwivedi to share views on policy making
Indore: Ministry of AYUSH has invited renowned homeopath practitioner of the city, Dr Ashwini Kumar Dwivedi to share his views in the ‘Global Forum on...

Miracles of classical homoeopathy book by Dr KJ Isaac released on February 10
THIRUVANANTHAPURAM: On his 86th birthday, Kerala’s homeopathy pioneer K J Isaac could not have hoped for a better gift. A book chronicling his life and...

A wart dissolved by Causticum
A Case Study A ten years old boy along with his mother came to me with the complaint of a small growth is present on...

Homeopathy & Squamous Cell Carcinoma Dr Prafulla Kumar Nayak
An old man of 72 years consulted homeopathy when the conventional medicine was of no use for him. But more than 200 year old Homeopathic...

BHMS Doctor in Multiple locations across India for NBS India Ltd
NBS India Ltd. – Mumbai, Maharashtra Urgent Opening for BHMS Doctors for Multiple Location ** Post: BHMS Doctor. Exp: 2-4 Yrs Ctc: 30,000-38,000/mnt Loc: Multiple...

Medical Officer (Homoeopathy) Vacancy in Andaman Nicobar Island with 85000 INR remuneration
Applications invited from eligible candidates for the post of General Duty Medical Officer (Homoeopathy) Vacancy in Andaman Nicobar Island Last date : 25th Feb 2017...
The Need For Quality Control and Quality Assurance of Homoeopathic Medicines
Introduction The Homeopathic Pharmaceutical products, as it is experienced so far, act as an essential vital segment of the health care and well being...

Govt National Institute of Homoeopathy (NIH) Jobs 2017-2018
National Institute of Homeopathy was established on 10th december 1975. National Institute of Homoeopathy (NIH) is an organisation under the Department of Ayurveda, Yoga &...



